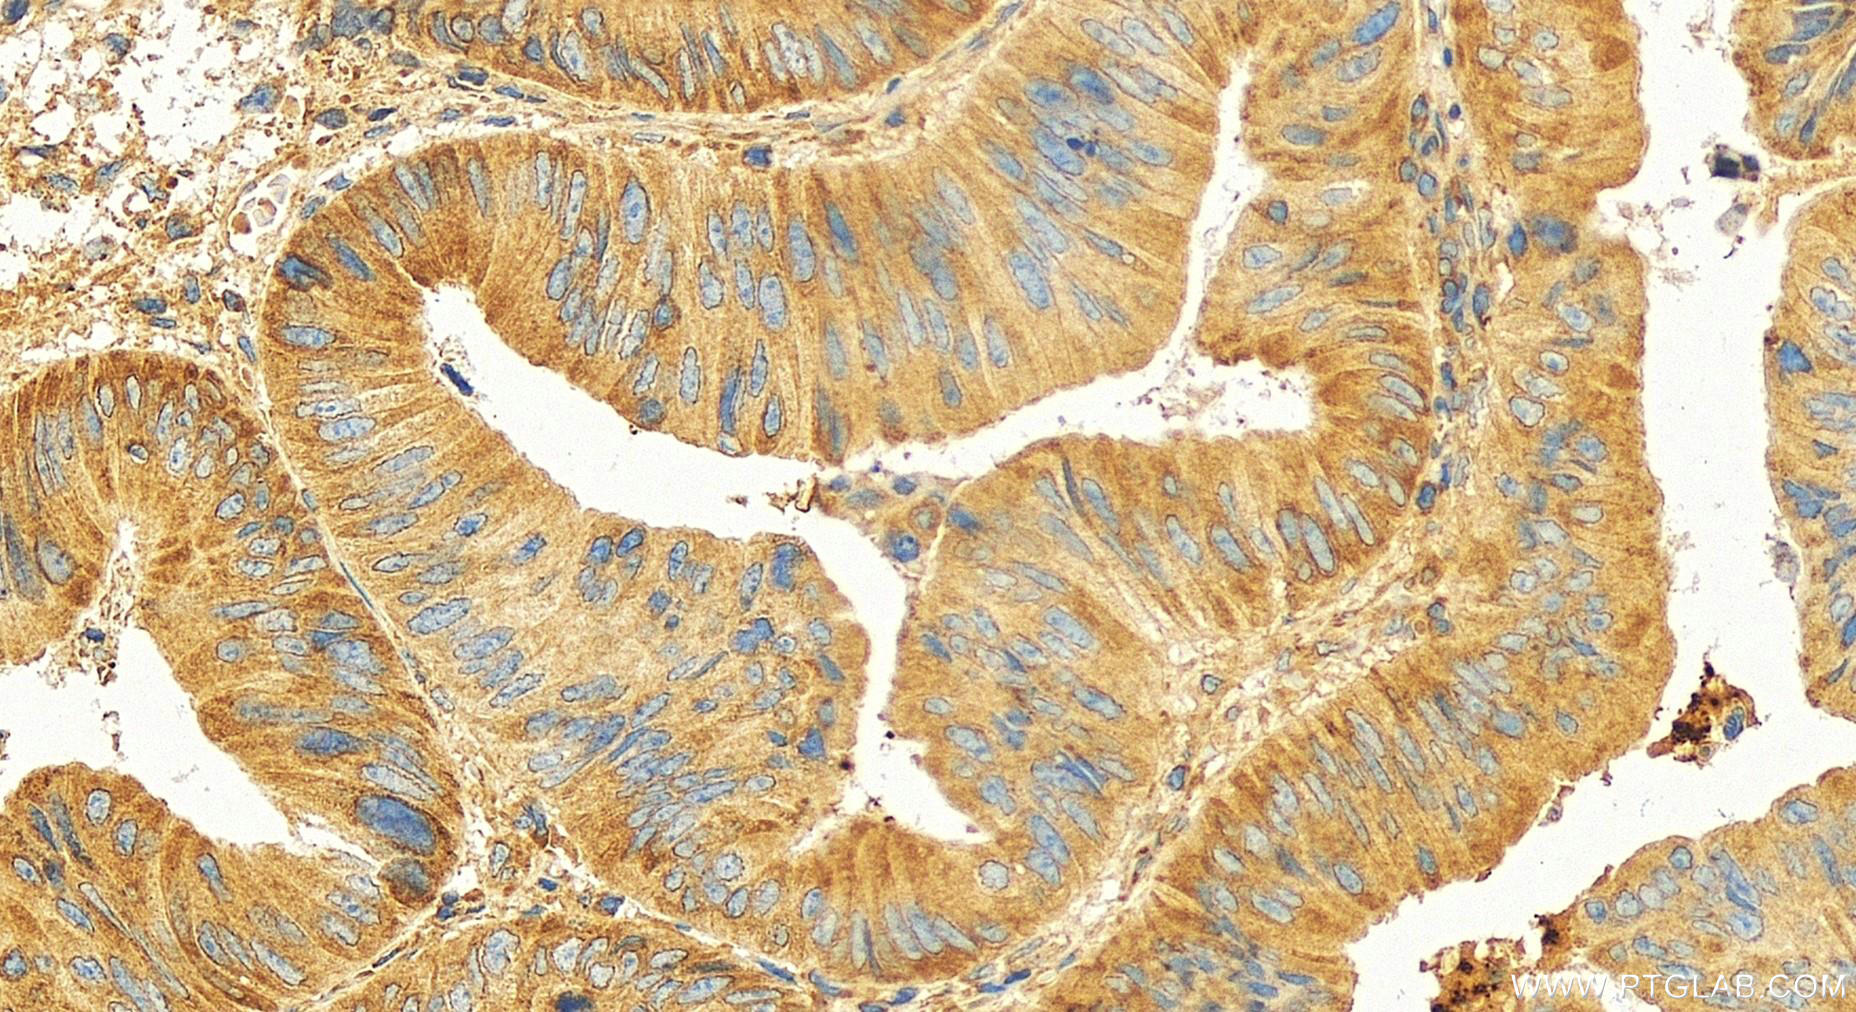
Immunohistochemical analysis of paraffin-embedded human colon cancer slide using 17040-1-AP (METAP2 antibody) at dilution of 1:100 (under 20x lens). Heat mediated antigen retrieval with Tris-EDTA buffer (pH 9.0). Immunohistochemistry (IHC) staining of human colon cancer using METAP2 Polyclonal antibody (17040-1-AP)

Tested Applications
| Positive WB detected in | HepG2 cells, MCF-7 cells, mouse pancreas tissue, mouse testis tissue |
| Positive IP detected in | MCF-7 cells |
| Positive IF/ICC detected in | HepG2 cells |
Recommended dilution
| Application | Dilution |
|---|---|
| Western Blot (WB) | WB : 1:500-1:1000 |
| Immunoprecipitation (IP) | IP : 0.5-4.0 ug for 1.0-3.0 mg of total protein lysate |
| Immunofluorescence (IF)/ICC | IF/ICC : 1:50-1:500 |
| It is recommended that this reagent should be titrated in each testing system to obtain optimal results. | |
| Sample-dependent, Check data in validation data gallery. | |
Published Applications
| KD/KO | See 1 publications below |
| WB | See 2 publications below |
Product Information
17040-1-AP targets METAP2 in WB, IHC, IF/ICC, IP, ELISA applications and shows reactivity with human, mouse, rat samples.
| Tested Reactivity | human, mouse, rat |
| Cited Reactivity | human, mouse |
| Host / Isotype | Rabbit / IgG |
| Class | Polyclonal |
| Type | Antibody |
| Immunogen |
CatNo: Ag10564 Product name: Recombinant human METAP2 protein Source: e coli.-derived, PGEX-4T Tag: GST Domain: 132-478 aa of BC013782 Sequence: GQECEYPPTQDGRTAAWRTTSEEKKALDQASEEIWNDFREAAEAHRQVRKYVMSWIKPGMTMIEICEKLEDCSRKLIKENGLNAGLAFPTGCSLNNCAAHYTPNAGDTTVLQYDDICKIDFGTHISGRIIDCAFTVTFNPKYDTLLKAVKDATNTGIKCAGIDVRLCDVGEAIQEVMESYEVEIDGKTYQVKPIRNLNGHSIGQYRIHAGKTVPIVKGGEATRMEEGEVYAIETFGSTGKGVVHDDMECSHYMKNFDVGHVPIRLPRTKHLLNVINENFGTLAFCRRWLDRLGESKYLMALKNLCDLGIVDPYPPLCDIKGSYTAQFEHTILLRPTCKEVVSRGDDY Predict reactive species |
| Full Name | methionyl aminopeptidase 2 |
| Calculated Molecular Weight | 478 aa, 53 kDa |
| Observed Molecular Weight | 67 kDa |
| GenBank Accession Number | BC013782 |
| Gene Symbol | METAP2 |
| Gene ID (NCBI) | 10988 |
| RRID | AB_2144162 |
| Conjugate | Unconjugated |
| Form | Liquid |
| Purification Method | Antigen affinity purification |
| UNIPROT ID | P50579 |
| Storage Buffer | PBS with 0.02% sodium azide and 50% glycerol, pH 7.3. |
| Storage Conditions | Store at -20°C. Stable for one year after shipment. Aliquoting is unnecessary for -20oC storage. 20ul sizes contain 0.1% BSA. |
Background Information
MetAP2, also known as MAP2, P67EIF2 or p67, is one of the three known methionine aminopeptidases responsible for the removal of the N-terminal translation initiator methionine from newly synthesized proteins, which is a critical step in protein maturation (PMID: 27692546, 16568094). The enzyme binds two cobalt or manganese ions in its active site (PMID: 11524009, 12718546). As higher MetAP2 expression was observed in tumor (mesothelioma, neuroblastoma, and colorectal carcinoma) cells compared with normal cells, the enzyme serves as a target for anti-angiogenic compounds of natural origin, such as fumagillin and ovalicin (PMID: 11485930, 15927358, 15102683, 9224570). Selective inhibition of MetAP2 stops vascularization and tumor growth in animal models (PMID: 12118091). MetAP2 has 3 isoforms with molecular mass of 50-53 kDa and apparent molecular mass 67 kD.
Protocols
| Product Specific Protocols | |
|---|---|
| IF protocol for METAP2 antibody 17040-1-AP | Download protocol |
| IHC protocol for METAP2 antibody 17040-1-AP | Download protocol |
| IP protocol for METAP2 antibody 17040-1-AP | Download protocol |
| WB protocol for METAP2 antibody 17040-1-AP | Download protocol |
| Standard Protocols | |
|---|---|
| Click here to view our Standard Protocols |
Publications
| Species | Application | Title |
|---|---|---|
Sci Adv Mechanism of cotranslational modification of histones H2A and H4 by MetAP1 and NatD.
| ||